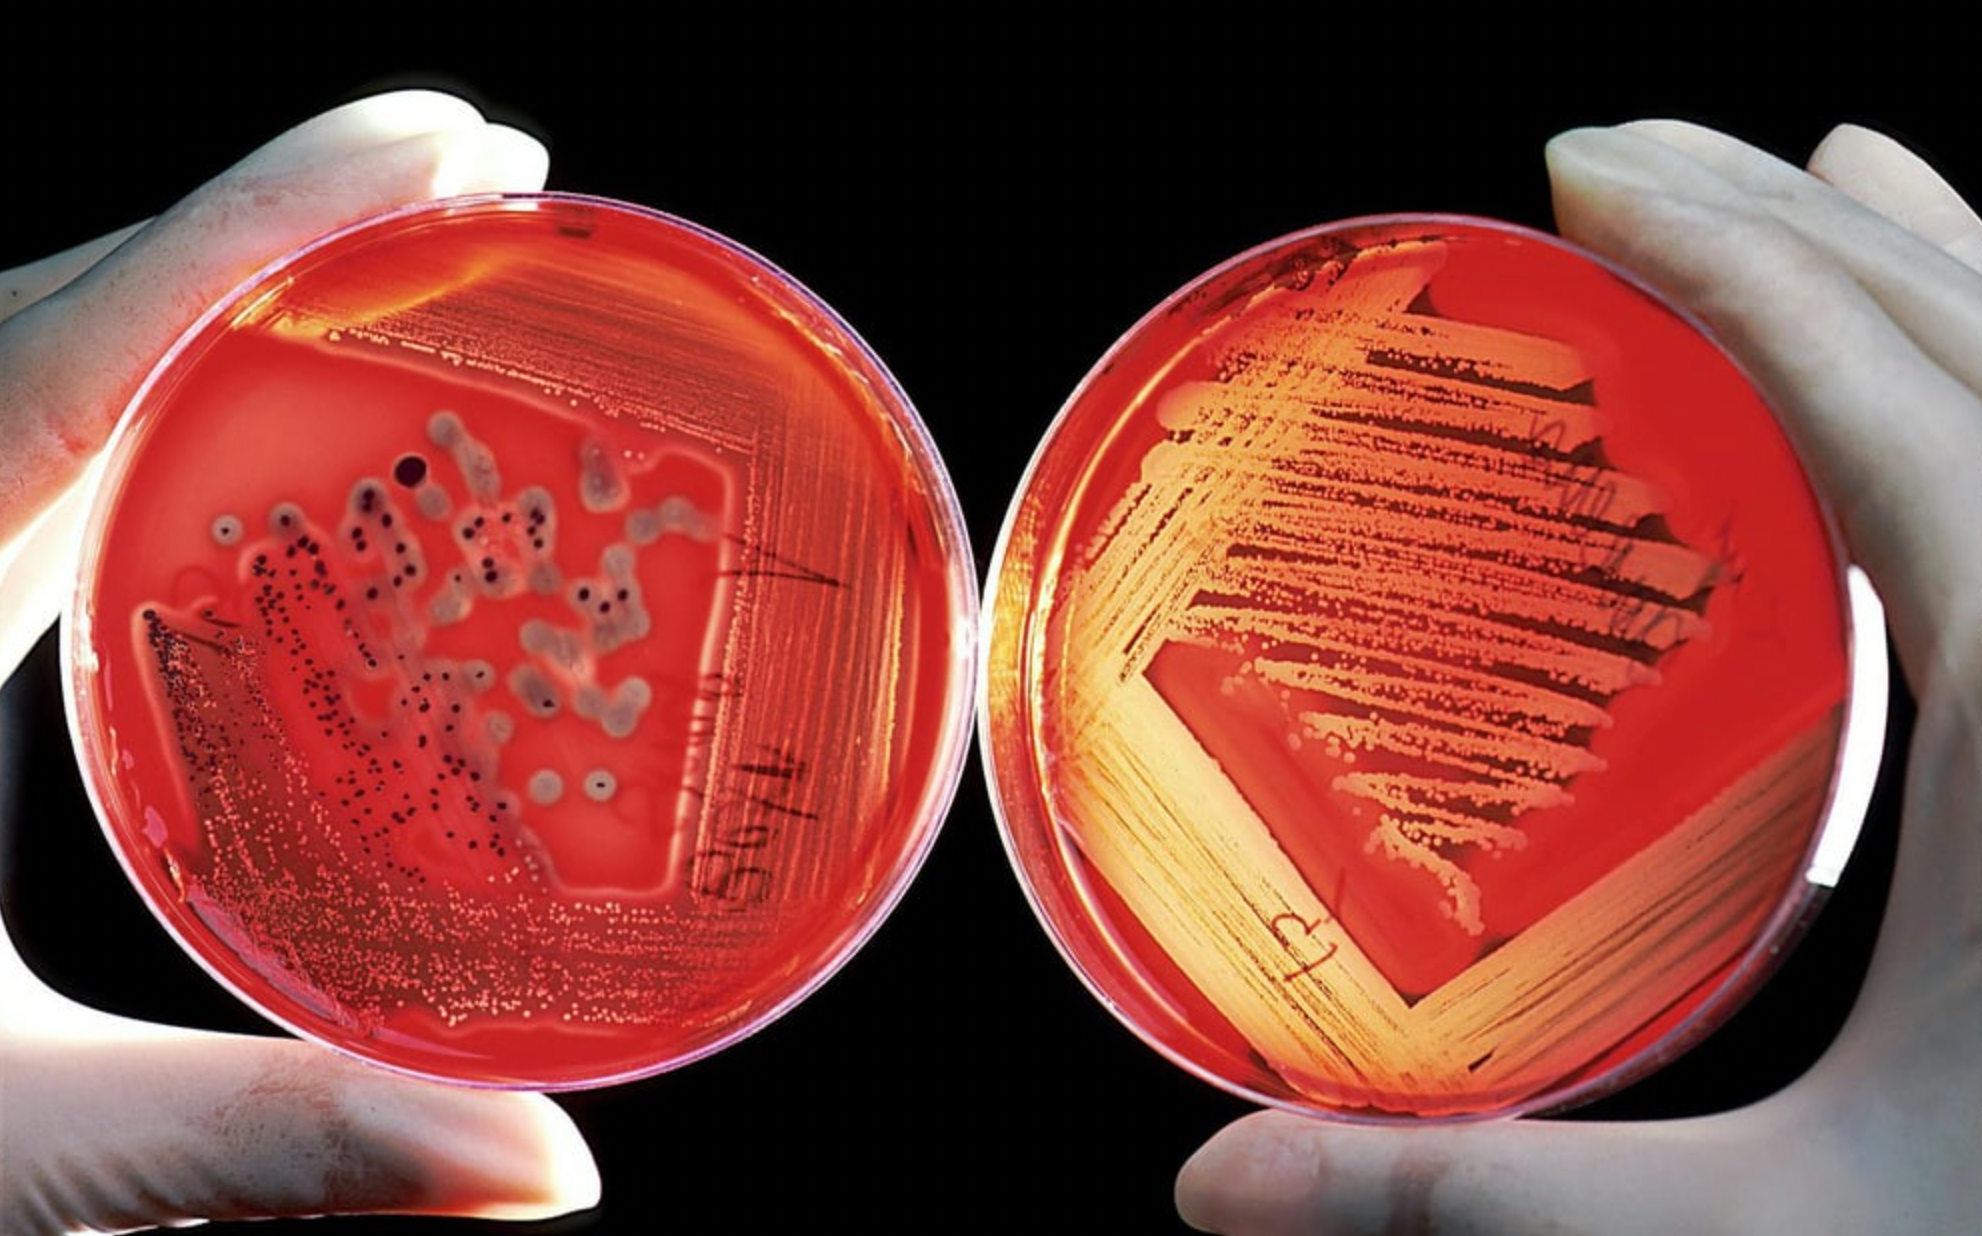
Der unsichtbare Schuldige: Porphyromonas gingivalis verstehen

PerioTrap Pharmaceuticals GmbH
Weinbergweg 22, 06120 Halle (Saale)
Dr. James Belcher, January 5, 2026
Porphyromonas gingivalis (P. gingivalis) is a tiny but powerful bacterium. It lives in dental plaque and is considered a keystone pathogen – a major player that can disrupt the entire oral microbiome. Instead of just causing damage itself, P. gingivalis influences other bacteria, making them more aggressive. The result: Gingivitis can lead to periodontitis – a disease that extends far beyond the gum line.
Porphyromonas gingivalis is an anaerobic bacterium that occurs naturally in the mouth. Although it is usually present only in small quantities, it can have a disproportionately large impact on the entire oral microbiome. Therefore, it is referred to as a "keystone pathogen"—a key organism that can disrupt the balance of the oral flora.
P. gingivalis has unique mechanisms by which it influences the immune system and intensifies inflammation. This allows other harmful bacteria to survive and multiply more easily. The result: chronic inflammation, bleeding gums, tissue loss, and, in later stages, periodontitis.
What makes this bacterium particularly dangerous is its ability to systemically influence inflammation. It has been linked to cardiovascular disease, diabetes, and even Alzheimer's – an indication of how significantly the mouth affects overall health.
P. gingivalis produces so-called virulence factors such as gingipains. These enzymes help the bacterium to spread in tissue, evade immune responses, and make other germs more pathogenic. This creates an "inflammatory ecosystem" that permanently activates the immune system.
Modern research shows that it is not the quantity of the bacterium that is crucial, but its effect on the entire microbial community. This is precisely where PerioTrap® technology comes in: It selectively blocks the pathogenic mechanisms of P. gingivalis without destroying the entire microbiome.
Even small amounts of P. gingivalis can be enough to trigger dysbiosis, which leads to periodontitis – therefore, it is considered one of the most important pathogens in dentistry.